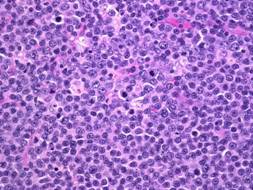

Microbial Diseases A to Z | Disease Home Page | Bio 406 Home Page | MicroWorld |

Burkitt’s lymphoma is a rare, aggressive form of Non-Hodgkin’s lymphoma (cancer of the lymphoid tissue). It affects the lymphocytes (B-cells), and is seen most often in male children and young adults. The jaw, CNS, bowel, kidneys, ovaries, and other organs may be affected.
Epstein-Barr virus
sudden onset of and can include: painless swelling of lymph nodes, fever, sore throat, bone and joint pain, night sweats, fatigue, weight loss, itching skin, recurring infections
biopsy of diseased site (bone marrow, lymph node)
may include chemo/radiation therapy, surgery (tumor removal), stem cell transplant, medications (prednisone, cyclophosphamide, ifosfamide, vincristine, cytarabine, doxorubicin, methotrexate, etoposide)
References/Links
Prepared by K. Moody